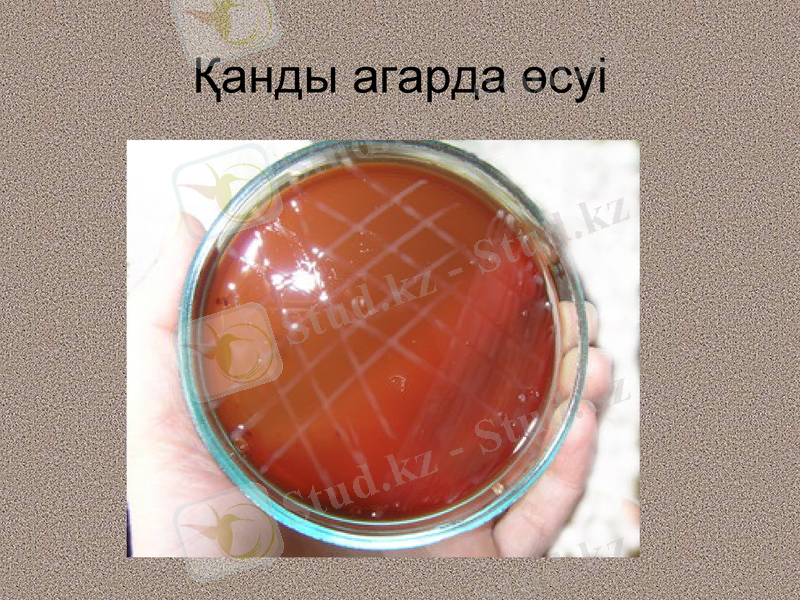
Slide 35

Вибриондар, кампилобактериялар және хеликобактериялар: морфологиясы, патогенезі, лабораториялық диагностика және профилактика мен емі



ҚазҰМУ Микробиология, вирусология және иммунология ЖАЛПЫ МЕДИЦИНА факультеті
Тырысқақтың микробиологиялық диагностикасы. Тырысқақ вибрионы. Кампилобактериялар
Геликобактериялар
Дәріскер: доц. Таурбаева Н. Т.

Жоспары
Вибриондар
Классификациясы
Морфологиясы
Дақылдық қасиеттері
Ферментативті қасиеттері
Антигендері
Лабораториялық талдау схемасы, дифференциациясы
Патогенділік факторлары
Клиникасы
Профилактикасы, емі
Кампиллобактериялар Классификациясы
Морфологиясы
Дақылдық қасиеттері
Ферментативті қасиеттері
Антигендері
Лабораториялық талдау схемасы, дифференциациясы
Патогенділік факторлары
Клиникасы
Профилактикасы, емі
Хеликобактериялар Классификациясы
Морфологиясы
Дақылдық қасиеттері
Ферментативті қасиеттері
Антигендері
Лабораториялық талдау схемасы, дифференциациясы
Патогенділік факторлары
Клиникасы
Профилактикасы, емі

Вибриондар

Тырысқақ - өте қауіпті жұқпалы ауру, ащы ішектің зақымдалуымен, су-тұз алмасуының бұзылуымен және жалпы интоксикациямен сипатталады.
Тырысқақ вибрионын 1883 жылы Кох ашты.
Індетті Vibrio cholerae О1 және О139 серологиялық топтарының өкілдері тудырады.
1906 ж - У. Готшлихтер Эль-Тор вибрионын ашты.

Классификациясы
Тұқымдастығы: VIBRIONACEAЕ- 4 туысы
Туыс: Vibrio
Түрі (21 түрі)
Аса маңызды :
- V. cholerae
- V. parahaemolyticus
- V. vulnificus
V. anguilarum
V. fischeri

Биоварианттары
- V. cholerae classic
V. cholerae eltor

МОРФОЛОГИЯСЫ
Үтір тәрізді иілген таяқшалар, ұсақтау.
Қозғалмалы (монотрих)
Спора (-)
Капсула (-)
Полиморфизм тән. Ескі дақылдарда - дәндер, шарлар, колботәріздес ұлғаю, L-пішін.

Тырысқақ вибрионы

Тырысқақ вибрионның морфологиясы

ДАҚЫЛДЫҚ ҚАСИЕТТЕРІ
Қоректік орталарға талғамсыз
Қарапайым қоректік орталарда жақсы өседі
Сілтіге төзімді
Аэробтар немесе факультативті анаэробтар
Колониялары аспан көк түсті, ұсақ
Тез өседі (сұйық орталарда - 6-8 сағ. )
1% пептонды суда - нәзік көгілдір қабықша түзіп лайлану
Сыртқы ортада төзімді - төмен температурада- 4-6 апта
Элективті орталары
1. Пептонды су - 6 сағаттан кейін қабықша пайда болады.
2. Сілтілі агар - ұсақ, аспан көк түсті колониялар түзеді.
3. TCBS агарында сары түсті колониялар түзейді.

Тырысқақ вибрионның колониялары(S және R-формалар)

Биохимиялық қасиеттері
Көмірсулар - қышқыл түзіп ферменттейді
Желатинді ыдыратады
Казеинді гидролиздейді
Нитраттарды қалпына келтіру және индолды негізде түзу (+) нитроза-индолды сынамасы - тырысқақ-рот реакциясы.

Хейберг триадасы
Биохимиялық қасиеттері бойынша тырысқақ қоздырғышының 2 биоварын анықтайды:
V. cholerae cholerae - классикалық
V. cholerae eltor - Эль-Тор
Хейберг барлық тырысқақ вибриондарды 8 топқа бөлді:
- Тырысқақ вибрионы бірінші топқа жатады. Манноза, сахароза - оң, арабиноза - теріс.

АНТИГЕНДІК ҚҰРЫЛЫМЫ
Н- Аг-түрспецификалық, барлық түрлері үшін ортақ
О-АГ- типоспецификалық (139 серотоп) .
тырысқақ қоздырғышы 0 1 топқа жатады
О1 АГ: 3 компоненттен түрады - А, В, С
- Огава серовары - А В
- Инаба серовары - А С
- Гикошима серовары - А В С
Агглютинацияланбаушы вибриондар О1 сарысуына қарсы - агглютинацияланбайды
Серотоп вибриондары 02, 03, 04- энтериттер мен гастроэнтериттердің қоздырғыштары.

ПАТОГЕНДІЛІК ФАКТОРЛАРЫ
1. Экзотоксин - холероген (цитотоксикалық әсер көрсетеді)
2. Эндотоксин (жасуша қабырғасының құрамындағы ЛПС), фагоцитоздан қорғайды.
3. Агрессия ферменттері (лецитиназа, фибринолизин, гиалуронидаза, нейраминидаза)

ТВ (талшық, муциназа ферменті ) →
энтероциттерге→ колонизация
( энтероциттерге енбейді) .
Холероген - функционалды тосқауыл. Холероген 2 суббірліктен тұрады - А және В. Ішек қуысында судың және хлоридтердің гиперсекрециясын туды-рады. Na кері сіңірілуін бұзады. Нәтижесінде диарея ағзаның сусыздануына әкеледі.

Холероген А (токсикалығы)
↓
аденилатциклазаның
активациялануы
↓
цАМФ көбеюі
↓
су-түз алмасуының бұзылуы
→сусыздану (күніне 30л) .
АТФ-аза→ жасуша ішілік транспорттың бұзылуы→ сусыздану және жасушааралық қатынастардың бұзылуы.

Ауру фазалары
1 фаза- энтерит
(қоздырғыштардың энтероциттерге адгезиясы және колонизациясы; нәжіс қайнатылған күріш сорпасына ұқсас)
2 фаза- гастроэнтерит
(құсу мен нәжістің бөлінуі ұлғаяды) ; сусыздану басталады.
3 фаза- тырысқақтық алгид
ағзаның толық сусыздануы.

Дегидратациялық синдром. Терінің тез зақымдалуы

Негізгі инфеция көзі науқас адам немесе бактерия тасымалдаушы болып табылады.
Эль-Тор тырысқағында ұзақ бактерия тасымалдаушылық байқалады.
Жұғу жолдары су және азық-түлік арқылы.
Таралу жолдары: фекалды-оральді, қарым-қатынастық
Эндемиялық аймақтар- Индияда Ганга және Брахмапутра өзендерінің бассейні.

Микробиологиялық диагностикасы
Барлық жұмыстар арнайы лабораторияда үздіксіз тәулік бойы қатал режимде жүргізіледі.
1. Бактериологиялық - негізгі әдіс
-
2. Жедел-диагностика- ИФР, ИФТ, ПТР,
3. Молекулярлы-генетикалық әдіс

1 кезең
1. Грам әдісімен бояу
2. люминесцентті микроскопия
3. 1% пептонды суға себу
4. сілтілі агары бар табақшалар
Монсур қоректік ортасы
агар (ТСЦС)

2 кезең
6 - 8 сағаттан соң
Сілтілі судағы өсуді зерттеу
2-ші пептондық суға қайталап егу
Грам әдісімен бояу
Ілінген тамшы (қозғалысы)

3 кезең
12-14 сағ кейін
Колонияларды зерттеу
Сілтілі агарда -S пішінді, аспан көк түсті, мөлдір.
Монсур ортасында - сұр-қара
ТСЦС - сары колониялар
Грам әдісімен бояу

4 кезең
18-24 сағаттан кейін
таза дақылдың қасиеттерін зерттейді
АР О-тырысқақ сарысуымен және типтелген сарысулармен (Огава және Инаба т. б. )
5 кезең
Идентификациялау үшін дақылдарды таңдау
6 кезең
36-48 сағаттан кейін
Тырысқақ вибрионының серотобын мен биовариантын анықтау

ЕМІ
1. Регидратация - жойылған сұйықтар мен электролиттерді қалпына келтіру(маңызды)
2. Этиотропты - кең спектрлі антибиотиктер (тетрациклиндер, фторхинолондар, хлорамфеникол)

Алдын алуы
Өлі тырысқақ вакцинасы
Біріктірілген тырысқақ вакцинасы (холероген - анатоксин + тырысқақ вибрионының О антигені)
Холероген-анатоксин
Вакцина егу эпидемиялық көрсеткіштер бойынша жүргізіледі.

Тырысқақ тәріздес вибриондар
Vibrio parahaemolyticus - Жапонияда жедел диарея қоздырғышы.
Инфекция көзі - су тағамдары, теңіз суы. Диарея 24 сағаттан соң басталады. Ауру спонтанды түрде басылады.

Vibrio vulnificus - Тынық және Атлант мұхитының жылы суларында мекендейді. Екі қабатты моллюскалардың (мидиялар) ағзасында шоғырланады.
Тағаммен қолданғанда септицемия туады, иммунитеті төмендеген адамдар зақымдалған терімен жанасқанда іріңді процесстер болады.

Campylobacter
.

Жіктелуі
Туқымдастығы: Campylobacteriaceae
Туыс Campylobacter өзіне 5 түрді біріктіреді
Адамға патогенділері:
C. jejuni- маңызы зор
C. fetus
C. coli
C. pylori кейін Helicobacter туыстастығына біріктірген
Антигендері: О-, Н
60-дан аса сероварлары бар.

МОРФОЛОГИЯСЫ
Жіңішке иілген таяқшалар “S” әрібіне ұқсас, немесе “шағала қанаты” тәрізді орналасады
Өте қозғалғыш - лофотрихтар талшықтары жасушаның 1 не 2 басында
Винт тәрізді қозғалыстармен сипатталады.
Грам (-)
Спора (-)
Капсула (-)
МИКРОАЭРОФИЛДЕР

ТӨЗІМДІЛІГІ
Сыртқы ортада көбеюге бейім, әсіресе су қоймаларында.
Жоғарғы температураға сезімтал.
Төменгі температурада ұзақ сақталады, мұздатылған етте бірнеше айға дейін.
Бөлме температурасында әртүрлі заттарда 2 аптаға дейін сақталады.
Асқазан сөліне және өтке төзімді, осы қасиет кампиллобактерлерге асқазан барьерін өтіп асқорыту жолында сақталуға мүмкіндік береді.

ДАҚЫЛДЫҚ ҚАСИЕТТЕРІ
Қоректік орталарға талғамды:
- жұлынды агар
- шоколадты агар
Колониялары:
- түссіз, мөлдір
- томпайған
Дақылдандыруды микроаэрофильді жағдайларда өткізеді.
Қанды агарда өсуі

Биохимиялық қасиеттері
Көмірсу Аминқышқылы Желатин Мочевина
↓ ↓ ↓ ↓
ыдыратпайды ыдыратады гидролиздемейді
(-) (+) (-)
каталаза және оксидазалық активтілігі бар
Патогендік факторлары:
Экзотоксин (термолабилді) → колония түзеді
Эндотоксин (термостабилді) → цито- және жалпы токсикалық әсер етеді.

Патогенезі
Кампиллобактериялар - ауыз қуысы - асқазан - ашы ішек - жабысу - колонизациялану - инвазия - ішек эпителийі бойымен қозғалуға мүмкіндік - қабынудың дамуы - шырышты қабықтың ісінуі - токсиндердің бөлінуі:
- Іс жүргізу
- Автоматтандыру, Техника
- Алғашқы әскери дайындық
- Астрономия
- Ауыл шаруашылығы
- Банк ісі
- Бизнесті бағалау
- Биология
- Бухгалтерлік іс
- Валеология
- Ветеринария
- География
- Геология, Геофизика, Геодезия
- Дін
- Ет, сүт, шарап өнімдері
- Жалпы тарих
- Жер кадастрі, Жылжымайтын мүлік
- Журналистика
- Информатика
- Кеден ісі
- Маркетинг
- Математика, Геометрия
- Медицина
- Мемлекеттік басқару
- Менеджмент
- Мұнай, Газ
- Мұрағат ісі
- Мәдениеттану
- ОБЖ (Основы безопасности жизнедеятельности)
- Педагогика
- Полиграфия
- Психология
- Салық
- Саясаттану
- Сақтандыру
- Сертификаттау, стандарттау
- Социология, Демография
- Спорт
- Статистика
- Тілтану, Филология
- Тарихи тұлғалар
- Тау-кен ісі
- Транспорт
- Туризм
- Физика
- Философия
- Халықаралық қатынастар
- Химия
- Экология, Қоршаған ортаны қорғау
- Экономика
- Экономикалық география
- Электротехника
- Қазақстан тарихы
- Қаржы
- Құрылыс
- Құқық, Криминалистика
- Әдебиет
- Өнер, музыка
- Өнеркәсіп, Өндіріс
Қазақ тілінде жазылған рефераттар, курстық жұмыстар, дипломдық жұмыстар бойынша біздің қор #1 болып табылады.



Ақпарат
Қосымша
Email: info@stud.kz